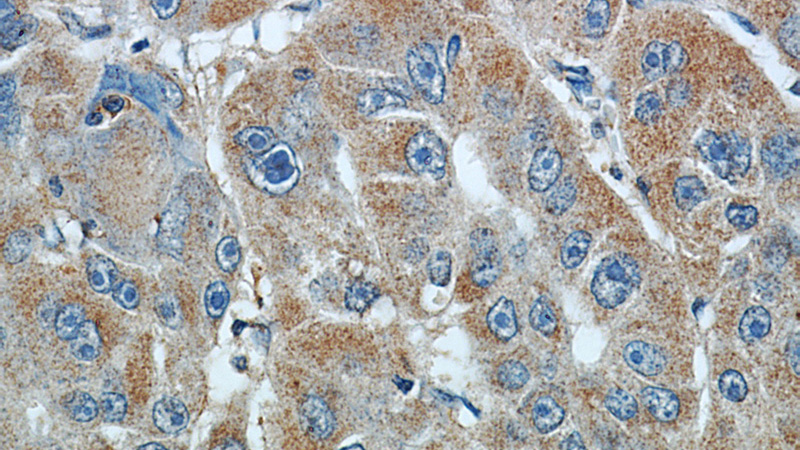
Immunohistochemical of paraffin-embedded human liver cancer using Catalog No:114005(PLOD2 antibody) at dilution of 1:50 (under 40x lens)

-
Product Name
PLOD2-Specific antibody
- Documents
-
Description
PLOD2-Specific Rabbit Polyclonal antibody. Positive FC detected in HeLa cells. Positive IF detected in Hela cells. Positive IHC detected in human liver cancer tissue, human pancreas tissue, human skeletal muscle tissue. Positive WB detected in DU 145 cells, HT-1080 cells, mouse liver tissue, mouse pancreas tissue, mouse testis tissue. Positive IP detected in mouse testis tissue. Observed molecular weight by Western-blot: 85 kDa
-
Tested applications
ELISA, WB, IHC, IF, IP, FC
-
Species reactivity
Human,Mouse,Rat; other species not tested.
-
Alternative names
LH2 antibody; Lysyl hydroxylase 2 antibody; PLOD2-Specific antibody; TLH antibody
-
Isotype
Rabbit IgG
-
Preparation
This antibody was obtained by immunization of PLOD2-Specific recombinant protein (Accession Number: NM_182943). Purification method: Antigen affinity purified.
-
Clonality
Polyclonal
-
Formulation
PBS with 0.02% sodium azide and 50% glycerol pH 7.3.
-
Storage instructions
Store at -20℃. DO NOT ALIQUOT
-
Applications
Recommended Dilution:
WB: 1:200-1:2000
IP: 1:200-1:2000
IHC: 1:20-1:200
IF: 1:10-1:100
-
Validations

DU 145 cells were subjected to SDS PAGE followed by western blot with Catalog No:114005(PLOD2 antibody) at dilution of 1:300

Immunohistochemical of paraffin-embedded human liver cancer using Catalog No:114005(PLOD2 antibody) at dilution of 1:50 (under 10x lens)
Immunohistochemical of paraffin-embedded human liver cancer using Catalog No:114005(PLOD2 antibody) at dilution of 1:50 (under 40x lens)

Immunofluorescent analysis of Hela cells, using PLOD2 antibody Catalog No:114005 at 1:25 dilution and Rhodamine-labeled goat anti-rabbit IgG (red).

IP Result of anti-PLOD2 (IP:Catalog No:114005, 4ug; Detection:Catalog No:114005 1:500) with mouse testis tissue lysate 5000ug.

1X10^6 HeLa cells were stained with 0.2ug PLOD2 antibody (Catalog No:114005, red) and control antibody (blue). Fixed with 90% MeOH blocked with 3% BSA (30 min). Alexa Fluor 488-congugated AffiniPure Goat Anti-Rabbit IgG(H+L) with dilution 1:1500.
-
Background
PLOD2,also named as LH2, forms hydroxylysine residues in -Xaa-Lys-Gly- sequences in collagens. It is a potential novel prognostic factor for HCC patients following surgery. Among the PLOD genes, PLOD2 contributes to cancer prognosis and angiogenesis. Several authors have reported that PLOD2 expression might provide prognostic information about malignant tumours such as glioblastoma. PLOD2 expression is a useful biomarker for the effects of antiangiogenic treatment for malignancy. (PMID:22098155). It has 2 isoforms produced by alternative splicing and seven glycosylation sites.This antibody is specific to PLOD2.
-
References
- Noda T, Yamamoto H, Takemasa I. PLOD2 induced under hypoxia is a novel prognostic factor for hepatocellular carcinoma after curative resection. Liver international : official journal of the International Association for the Study of the Liver. 32(1):110-8. 2012.
- Remst DF, Blaney Davidson EN, Vitters EL. Osteoarthritis-related fibrosis is associated with both elevated pyridinoline cross-link formation and lysyl hydroxylase 2b expression. Osteoarthritis and cartilage / OARS, Osteoarthritis Research Society. 21(1):157-64. 2013.
- Eisinger-Mathason TS, Zhang M, Qiu Q. Hypoxia-dependent modification of collagen networks promotes sarcoma metastasis. Cancer discovery. 3(10):1190-205. 2013.
- Remst DF, Blaney Davidson EN, Vitters EL, Bank RA, van den Berg WB, van der Kraan PM. TGF-ß induces Lysyl hydroxylase 2b in human synovial osteoarthritic fibroblasts through ALK5 signaling. Cell and tissue research. 355(1):163-71. 2014.
- there was a problem with your PMID, try again.
- Remst DF, Blom AB, Vitters EL. Gene expression analysis of murine and human osteoarthritis synovium reveals elevation of transforming growth factor β-responsive genes in osteoarthritis-related fibrosis. Arthritis & rheumatology (Hoboken, N.J.). 66(3):647-56. 2014.
- Chen Y, Terajima M, Yang Y. Lysyl hydroxylase 2 induces a collagen cross-link switch in tumor stroma. The Journal of clinical investigation. 125(3):1147-62. 2015.
Related Products / Services
Please note: All products are "FOR RESEARCH USE ONLY AND ARE NOT INTENDED FOR DIAGNOSTIC OR THERAPEUTIC USE"
